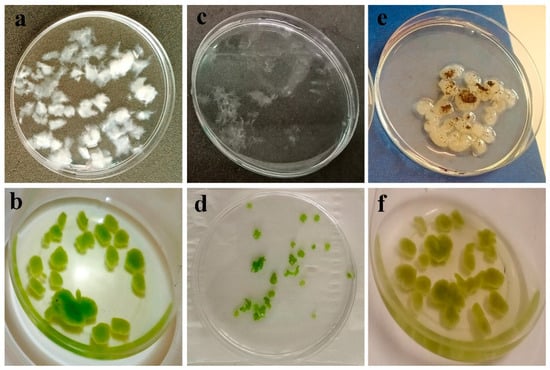

Abstract
Microalgae cultivation is often limited by the high cost and inefficiency of harvesting, making it a major barrier to large-scale resource recovery. Traditional methods such as centrifugation or chemical flocculation are expensive and environmentally unsustainable. As a biological alternative, filamentous fungi can form pellets or hyphal networks that entrap microalgae cells via bio-flocculation, facilitating easier separation from the culture medium. This study aimed to optimize culture conditions for fungal pellet formation and develop effective microalgae–fungal composites for improved harvesting. Fungal isolates including Aspergillus niger, A. fumigatus, A. flavus, and unidentified strains were screened for their pelleting capacity and nutrient removal efficiency. Through OVAT analysis, key factors such as pH, agitation speed, carbon source, and C:N ratio were found to significantly influence pellet formation. One isolate (FP) showed strong potential, forming pellets under stationary conditions and performing best at neutral to alkaline pH. Molecular analysis identified FP as a fungal consortium containing members of Ascomycota, Mucoromycota, Basidiomycota, and Rozellomycota. When applied to cocoa pulp wastewater, the microalgae–fungi composites outperformed monocultures in reducing NH4+-N, COD, and PO43−-P. Interestingly, microalgae delayed fungal sporulation. These findings highlight the potential of fungal consortia in enhancing both microalgae harvesting and wastewater bioremediation.
1. Introduction
In Ghana, the world’s second-largest producer of cocoa beans, traditional cocoa bean processing generates substantial waste streams, including food processing effluents (FPEs) from industries producing chocolate and upcycled cocoa fruit juice. These effluents, which consist of residual cocoa pulp and other by-products, are increasingly discharged into the environment, posing significant environmental challenges [1]. While conventional wastewater treatment methods such as activated sludge, chemical precipitation, nitrification, and denitrification have been somewhat effective, their high energy consumption and environmental impact highlight the need for more sustainable alternatives. Microalgae-based wastewater treatment technologies have emerged as promising solutions due to their low carbon footprint, potential for nutrient recovery, and alignment with circular bioeconomy principles [2,3].
Microalgae-based wastewater treatment (WWT) technology is increasingly recognized as a sustainable and efficient solution for treating industrial effluents, particularly in the agriculture and food processing sectors. This technology offers numerous advantages, including improved nutrient uptake, biomass production, and reduced greenhouse gas emissions [4]. Microalgae are highly effective at absorbing excess nutrients, such as nitrogen and phosphorus, from wastewater, thus mitigating the risk of eutrophication in nearby water bodies. Additionally, microalgae biomass can be converted into valuable biofuels, animal feed, or other bioproducts, promoting a circular bioeconomy model. Despite these advantages, recovering microalgae from treated effluents remains one of the most significant challenges in scaling up microalgae-based WWT systems.
Microalgae are characterized by their small size, low density, and continuous suspension in water, which complicates the recovery process. These characteristics make it difficult to harvest microalgae from large volumes of treated effluents effectively, and as a result, harvesting costs represent 20–30% of the total cost of biomass production [5]. Traditional methods of harvesting, such as flocculation, which relies on the addition of chemicals to aggregate microalgae into larger clusters, and centrifugation, which uses high-speed spinning to separate microalgae from water, are commonly employed. However, these methods are often inefficient, costly, and require significant energy input, making them less viable for large-scale operations [6].
To address these challenges, there is an increasing interest in biological approaches to harvesting, such as fungal-assisted flocculation [7], which offers the advantage of easy retrieval from wastewater. This method involves using fungal mycelium to aggregate microalgae into larger flocs, which can then be easily removed from the water. Fungal-assisted flocculation is considered more eco-friendly, as it reduces the need for chemicals and minimizes the environmental impact associated with traditional methods. Moreover, it is cost-effective and energy-efficient, offering a sustainable solution to the high operational costs of microalgae recovery. Other biological harvesting methods, such as the use of bacterial flocculation [8], are also being explored to optimize the harvesting process further and reduce costs. Co-culturing microalgae with fungi has shown significant promise in enhancing wastewater treatment and facilitating the harvesting process. This approach benefits from the synergistic relationship between microalgae and fungi, where both organisms contribute to the removal of nutrients and heavy metals from wastewater. Microalgae are excellent at absorbing excess nutrients, including nitrogen and phosphorus, while fungi can assist in aggregating microalgae into larger flocs, making them easier to harvest. This combined action can lead to improved overall efficiency in nutrient and pollutant removal, making the process more effective compared to traditional methods [9].
To maximize the potential of microalgae–fungi co-cultivation, optimizing various culture conditions is crucial. Factors such as carbon sources, pH, agitation speed, and the carbon-to-nitrogen ratio are all critical in the growth and metabolic activity of both organisms. Additionally, using organic waste streams as nutrient sources can further reduce operational costs and support a more sustainable model by recycling waste. These optimizations aim to create a cost-effective and sustainable solution for both microalgae–fungi co-cultivation and the subsequent harvesting of microalgae [10,11].
This study aimed to explore the formation of fungal pellets as a cost-effective method for microalgae harvesting. Various fungal isolates were screened under different cultivation conditions to identify the optimal conditions for pellet formation. The isolates that produced the highest number of pellets were then evaluated for their efficiency in harvesting microalgae. These fungi were subsequently tested in real wastewater to assess their ability to remove nutrients. The study compared the nutrient removal capabilities of both microalgae–fungi consortia and individual monocultures. Additionally, the environmental significance and resource recovery potential of the findings were emphasized. The results are of considerable importance to the scientific community, particularly in the fields of biological wastewater treatment and large-scale microalgae cultivation.
2. Materials and Methods
2.1. Microalgae Culture
A wastewater-borne green microalgae that was isolated in a previous study [9] was used in this experiment. The cultures were maintained in BG-11 medium under autotrophic conditions at a room temperature of 25 °C and a light intensity of 4000 lux illumination under a 14/10 h light/dark photoperiod.
2.2. Fungi Culture
Refrigerated cultures of eleven fungal isolates were obtained from the Natural Products Laboratory at the Department of Biochemistry, University of Ghana. Aliquots of the cultures were diluted in sterile deionized water and revived by spread plating onto Potato Dextrose Agar (PDA) plates and incubated for 3–5 days at 37 °C until sporulation was observed. With a sterile loop, the single sporing technique was applied to lightly scrape off spores from the plates aseptically onto PDA slants [10,11]. The slants were observed daily for uniformity and contamination. The spores were then harvested from the slants using a 1% Tween-20 solution. The Tween-20-spore stock was distributed into sterile 15 mL Falcon tubes and preserved in a refrigerator for later use. The spore densities of the stocks were determined by optical density (OD) using a spectrophotometer and a spore count using a hemocytometer.
2.3. Experimental Setup
Rigorous experiments were conducted to optimize the cultivation conditions and enhance the performance of fungal isolates related to pellet formation. The assessment criteria included pellet number, size, and harvesting efficiency. Samples were examined using scanning electron microscopy (SEM) to observe pellet formation, and biochemical analyses were performed to evaluate metabolic activity. The fungal isolate demonstrating the highest metrics in these categories was identified as the superior candidate, and a 16S gene library was constructed to accurately identify the isolate. Subsequently, the performance of the selected fungal isolate and its complex interactions with microalgae were investigated using real wastewater collected from a cocoa processing factory located in Ghana’s rainforest zone (CS-2026-2263). 10 L of the untreated effluents were collected and transported on ice to the laboratory. The initial physicochemical parameters of the cocoa pulp wastewater (CPW) were recorded. The wastewater was filtered through a sieve mesh (0.9 mm) to remove excess pulp and suspended solid matter. The pH of the filtered CPW was adjusted to 7, then transferred into 2 L Schott bottles, and autoclaved (121 °C, 15 min, Raypa, Terrassa, Barcelona, Spain, AES-150).
Four batch cultures were set up for a 10-day cultivation period. 500 mL Erlenmeyer flasks were used with a 300 mL working volume of CPW. The first batch was inoculated with an algal culture cell suspension and denoted as Algae. The second batch was inoculated with a suspension of fungal spores and designated as Fungi. In the third batch, both algal cells and fungal spores were introduced, forming a co-culture labeled Algae + Fungi. The fourth batch remained uninoculated and served as the control (Control). Each batch culture was prepared in triplicate. During the 10-day cultivation period, PO43−-P, NH4+-N, pH, and COD were recorded every other day to observe nutrient removal efficiencies of the mono- and co-cultures. Pellet formation was observed under various conditions and used as a criterion for selecting the best candidate isolate for further investigation. Enzyme activity and harvesting efficiencies of these isolates were also assessed in this study.
2.4. Optimization Tests for Fungal Pellet Formation
Briefly, 20 μL aliquots of the fungal isolates were added to slanted 50 mL Falcon tubes containing 20 mL of minimal media (Table S1). Five sets of optimization conditions were established in triplicate, using OVAT (one-variable-at-a-time) analysis. The criteria used in the selection of the most effective fungal isolate(s) are as follows:
2.4.1. Pellet Formation Under Stationary and Shaking Conditions
The fungal cultures were incubated under both shaking (80 rpm) and stationary (bench) conditions for a duration of 48 h. The tubes with fluffy suspensions were singled out as isolates capable of forming pellets.
2.4.2. Pellet Formation Under Different pH Conditions
The pH of the minimal media was adjusted with NH4Cl and KOH to obtain three pH conditions (pH 5, 7, and 9). Selected isolates were further screened by subjecting the cultures to the three pH conditions, representing acidic, neutral, and alkaline environments.
2.4.3. Pellet Formation Under Different Inoculum Sizes
Various volumes of fungal spore suspensions were determined to achieve ratios of 10, 50, and 500 times the volume of the culture media (denoted as 10×, 50×, and 500×, respectively). These were then introduced into the culture media and subjected to stationary and shaking conditions.
2.4.4. Pellet Formation Under Different Carbon Sources
Four distinct minimal media formulations were prepared, with sucrose, glucose, fructose, and galactose as the primary carbon sources [12]. The isolates were individually introduced into the minimal media containing various carbon sources. Pellet formation among the isolates was observed.
2.4.5. Pellet Formation Under Different Carbon-Nitrogen (C:N) Ratios
Three distinct minimal media formulations were established, with adjustments made to achieve the carbon-nitrogen (C:N) ratios of 1, 25, and 50. This adjustment was achieved through the calculation of the molar ratio between carbon, as represented by sucrose (C12H22O11), and nitrogen, derived from ammonium sulfate ((NH4)2SO4), in the formulation of the culture media. Consequently, the C:N ratio was controlled using their respective molar masses to achieve the desired ratios. Pellet formation was observed among the isolates and served as a selection criterion.
2.5. Enzyme Activity and Total Reducing Sugars
Fungi demonstrate the capacity to harness carbon reservoirs stored within microalgal cell walls, owing to the secretion of various extracellular enzymes during their growth, including cellulolytic enzymes [13]. While the composition of microalgal cell walls varies among species due to genetic regulation, cellulose emerges as a predominant constituent across diverse microalgal species [5]. In this study, the ability of two isolates, FP and T10, to catalyze the breakdown of sucrose into glucose and fructose was assessed using Aspergillus niger (Fluka®, 0.64 U/mg). In a set of Erlenmeyer flasks containing various concentrations of cellulose (0.2, 0.4, 0.6, 0.8, 1.0), along with 2.5 mg/mL of enzyme, 200 μL of enzyme solution was added to each flask. They were all buffered with 4 mM sodium acetate (NaAC) at pH 4.8. Glucose concentrations, indicative of hydrolysis yield, were determined using the 3,5-dinitrosalicylic acid (DNS) assay [14] at an absorbance of 540 nm, calibrated against a glucose standard curve. Hydrolysis yield was quantified as milligrams of reducing sugar per gram of dry-weight cellulose. Each assay was conducted in duplicate.
2.6. Harvesting Efficiency Estimation
After 48 h, the cultures containing fungal fluffs in the Falcon tubes were delicately transferred into conical flasks containing microalgae cultures at a 1:5 ratio. These flasks were then agitated in an orbital shaker (VWR, Radnor, PA, USA) to facilitate interaction between the fungal fluffs and the microalgal cells [15]. The initial OD at 680 nm (OD680) was recorded at 0 and at 30 min intervals (time (t)). The change in OD680 was used to determine the harvesting index (HI) and harvesting efficiency (HE) of the isolates. The isolate with the highest HE was chosen for the subsequent phase of the study. Equations (1) and (2) were used to calculate the HI and HE, where ٨t is the OD680 at time t and ٨0 is the initial OD680 value, respectively.
HI = (1 − ٨t/٨0)
HE (%) = HI × 100
2.7. Nutrient Removal Efficiency
To monitor the effluent polishing ability of the fungal isolates, 10 mL of the culture media was drawn with a syringe and filtered through 0.45 μm membrane filters (Xinya 50 mm, Shanghai, China) before analysis. Physicochemical parameters, including alkalinity, chloride, COD, ammonium (NH4+-N), and phosphates (PO43−-P), were analyzed every other day. COD, NH4+-N, and PO43−-P were measured using the potassium dichromate, Nessler reagent spectrophotometry, and ammonium molybdate spectrophotometry methods, respectively. All protocols were performed according to standard methods [16]. Nutrient removal efficiencies (NRE, %) were calculated according to Equation (3), where Pi = initial parameter value; Pf = final parameter value.
NRE = ((Pf − Pi)/Pi) × 100%
2.8. High-Throughput 16S rRNA Gene Amplicon Sequencing
16S rRNA analysis was used to confirm the identity of the fungal isolate through the following steps: DNA extraction, amplification of the 16S rRNA gene via PCR, 16S gene library construction, quantification, and sequencing. Subsequent steps included sequence processing, clustering of operational taxonomic units (OTUs), alignment of representative tags, and biological classification.
2.8.1. DNA Extraction
Total community genomic DNA was extracted using an E.Z.N.A™ Mag-Bind Soil DNA Kit (Omega, M5635-02, Norcross, GA, USA), following the manufacturer’s instructions. DNA concentration was measured using a Qubit 4.0 (Thermo, Waltham, MA, USA) to ensure that adequate amounts of high-quality genomic DNA were extracted.
16S rRNA Gene Amplification by PCR
The 16S rRNA V3–V4 amplicon was amplified using 2×Hieff® Robust PCR Master Mix (Yeasen, 10105ES03, Shanghai, China). Two universal bacterial 16S rRNA gene amplicon PCR primers, namely the forward primer (CCTACGGGNGGCWGCAG) and the reverse primer (GACTACHVGGGTATCTAATCC) (PAGE purified), were used. The reaction was set up as follows: microbial DNA (10 ng/μL) 2 μL; amplicon PCR forward primer (10 μM) 1 μL; amplicon PCR reverse primer (10 μM) 1 μL; 2×Hieff® Robust PCR Master Mix (Yeasen, 10105ES03, China) (total 30 μL). The plate was sealed and PCR was performed in a thermal instrument (Applied Biosystems 9700, Foster City, CA, USA) using the following program: 1 cycle of denaturing at 95 °C for 3 min, first 5 cycles of denaturing at 95 °C for 30 s, annealing at 45 °C for 30 s, elongation at 72 °C for 30 s, then 20 cycles of denaturing at 95 °C for 30 s, annealing at 55 °C for 30 s, elongation at 72 °C for 30 s and a final extension at 72 °C for 5 min. The PCR products were checked using electrophoresis in 2% (w/v) agarose gels in Tris, boric acid, EDTA (TBE) buffer, stained with ethidium bromide (EB) and visualized under UV light.
16S Gene Library Construction, Quantification, and Sequencing
Hieff NGS™ DNA Selection Beads (Yeasen, 10105ES03, China) were used to purify the free primers and primer dimer species in the amplicon product. Samples were delivered to Sangon BioTech (Shanghai, China) for library construction using a universal Illumina adaptor and index. Before sequencing, the DNA concentration of each PCR product was determined using a Qubit® 4.0 Green double-stranded DNA assay and quality controlled using a bioanalyzer (Agilent 2100, Santa Clara, CA, USA). The amplicons from each reaction mixture were pooled in equimolar ratios based on their concentration. Sequencing was performed using the Illumina MiSeq system (Illumina MiSeq, San Diego, CA, USA), according to the manufacturer’s instructions.
Sequence Processing, Operational Taxonomic Units Clustering, Representative Tags Alignment, and Biological Classification
After sequencing, the two short Illumina readings were assembled using PEAR Software (version 0.9.8) according to the overlap, and fastq files were processed to generate individual fasta and qual files, which could then be analyzed using standard methods. The effective tags were clustered into operational taxonomic units (OTUs) of 97% similarity using Usearch software (version 11.0.667). Chimeric sequences and singleton OTUs (with only one read) were removed, after which the remaining sequences were sorted into each sample based on the OTUs. The tag sequence with the highest abundance was selected as a representative sequence within each cluster. Bacterial and fungal OTU representative sequences were classified taxonomically by blasting against the RDP Database and UNITE fungal ITS Database, respectively.
Scanning Electron Microscope Imaging
Samples were centrifuged and fixed with 2.5% glutaraldehyde (4 °C, 8 h). Subsequently, the samples were washed three times with 0.1 M phosphate buffer saline (PBS) and fixed in 1% osmium tetroxide (OsO4) for 2 h after which they were washed with 0.1 M PBS three more times. This was then followed by graded dehydration using ethanol (30%, 50%, 70%, 80%, 90%, and 100%). The samples were stored in 50 mL Falcon tubes in a desiccator until completely dried. SEM images were taken with a scanning electron microscope (FEI Quanta 250FEG, Hillsboro, OR, USA). The element distribution of samples was obtained using an energy-dispersive X-ray (EDS) spectroscope [17].
2.9. Statistical Analysis
Data were expressed by means ± standard deviations. Statistically significant differences among means were assessed using one-way analysis of variance (ANOVA) with Tukey’s post hoc test or t-test. Results were significantly different when p < 0.05.
3. Results and Discussion
3.1. Optimization and Acclimatization of Fungal Isolates to Varying Culture Conditions
Eleven (11) fungal isolates were screened for their pelleting ability under stationary (0 rpm) and shaking conditions (80 rpm). Inoculum size (×10, ×50 and ×500) and carbon sources (sucrose, glucose, fructose, and galactose) were varied, as well as the C:N ratio (1, 25 and 50). The isolates’ performance under these conditions was subsequently reported in Section 3.1.1, Section 3.1.2, Section 3.1.3, Section 3.1.4 and Section 3.1.5. Isolates forming distinct “fluffs” within 48 h were identified as potential pellet-forming fungi.
3.1.1. Effect of Agitation
Previous studies have indicated that agitation plays a significant role in pellet formation by promoting mycelial aggregation under slight pressure [18]. However, both excessive agitation (i.e., G > 30 s−1) and insufficient agitation (i.e., G < 20 s−1) are known to be unfavorable [19]. This finding aligns with a study by Nasir et al. [20], which showed that a shaking speed of 125 rpm was most effective in producing uniformly shaped pellets of Aspergillus niger. Interestingly, this study observed the formation of fluffs at both 0 rpm and 80 rpm, with more pellets produced under shaking conditions. These results agree with the findings of Srinuanpan et al. [21], who found that a shaking speed of 80 rpm was optimal for promoting the growth of Trichoderma reesei QM 9414 and Aspergillus niger ATCC6375, resulting in larger pellets, while higher shaking speeds led to a reduction in pellet size. These observations suggest notable distinctions between stationary and shaking conditions in terms of pellet formation.”
After 48 h, four isolates (T10 (Aspergillus fumigatus), E16 (Aspergillus niger), “Producer” (Aspergillus flavus), and FP (an unknown isolate) formed distinct fluffs under both stationary and shaking conditions, while one isolate “Red ex” (unidentified fungal strain producing a reddish exudate) only produced fluffs under shaking conditions. Scores were assigned for selection (Table 1). The remaining six isolates only sporulated after five days without forming pellets. Given that the agitation rate also affects oxygen supply [15], which is a crucial factor influencing pellet formation, the varied results in this study might be attributed to species-specific demands. Among the five fluff-producing isolates, additional screening revealed that only T10 and FP exhibited significantly countable fluffs and were selected for further analysis.

Table 1.
Scoring criteria for screening pellet formation in fungal isolates.
3.1.2. Effect of pH
The impact of pH on pellet formation in microalgae–fungi co-cultures has been thoroughly studied, confirming that pH significantly influences pellet formation. Therefore, this study also examined pellet formation under acidic (pH 5), neutral (pH 7), and alkaline (pH 9) conditions (Figure 1a–c,n–p). Specifically, it was observed that acidic conditions promote pellet formation, whereas alkaline conditions do not. However, very low pH levels are also known to harm microalgae and fungi cultures (Figure 1a–c,n–p). On one hand, the optimal pellet formation at pH 5 (p < 0.05) in this study may be because lower pH levels neutralize the zeta potential, promoting electrostatic neutralization and enhancing fungal hyphal growth and spore aggregation, thereby improving pellet formation efficiency. Additionally, acidic conditions favor fungal hyphae growth by providing more binding sites [22] and accelerating fungal spore aggregation [23], which influences the HE. However, some studies have highlighted opposing opinions, suggesting that extremely low pH (i.e., pH 3 and below) can hinder pellet formation, as distinct pellets form at higher pH, compared to the freely dispersed mycelium seen at very acidic pH levels [24]. It has also been shown that the optimal pH for the growth of Aspergillus oryzae DAR 1679 and 3863 is between 4.5 and 5.5, while a lower pH of 3.5 to 4.5 is better suited for the growth of A. oryzae DAR 3699 [25].

Figure 1.
Optimization of factors influencing pellet formation under stationary (0 rpm) vs. shaking conditions (80 rpm). X-axes are the treatment groups, and y-axes are the number of pellets formed. The black and gray bars represent the FP and T10 isolates, respectively. Asterisks (*) indicate significant variations compared to the control (* p < 0.05, ** p < 0.01, *** p < 0.001, **** p < 0.0001). (a–c,n–p) = pellet formation under varying pH conditions; (d–f,q–s) = pellet formation under varying inoculum sizes; (g–j,t–w) = pellet formation under varying carbon sources; (k–m,x–z) = pellet formation under varying carbon:nitrogen ratios.
Conversely, some studies suggest that alkaline conditions promote flocculation [26,27] due to increased hydrophobicity. Alkaline environments enhance the hydrophobicity of fungal cells by altering the surface charge and lipid composition of the cell membranes, encouraging aggregation into larger clumps or flocs. Other research also reports that pH has little effect on pellet formation [20,28,29]. In this study, the isolates T10 and FP performed considerably well under alkaline conditions (Figure 1a–c,n–p), indicating their potential for easy application in real wastewater treatments. Thus, the effect of pH on pellet formation depends on fungal species and other culture conditions. This agrees with Prajapati et al. [30], who demonstrated that the influence of pH on bio-flocculation varies by species, with different cell genotypes showing distinct sensitivities to pH levels. Ultimately, selecting fungi that are adaptable across a broad pH range is vital, especially given microalgae’s preference for alkaline environments. Despite the highest floc production at pH 5 (p < 0.05) in this study, fungal mycelia growth was adequate at all pH levels (Figure 1a–c,n–p), suggesting that co-cultivation with other microorganisms, such as microalgae and bacteria, remains feasible.
3.1.3. Effect of Inoculum Size
Variations in inoculum size (both in terms of optical density and cell count) were explored for the two selected fungal isolates (T10 and FP), with volumes of 10×, 50×, and 500× the culture media tested (Figure 1d–f,q–s). Notably, 50× resulted in bigger and more compact biomass, while 500× formed a mucilaginous mat with numerous spores. A smaller inoculum size (10×) was ideal for optimal pellet formation, as individual fungal fluffs could be counted. No distinct pellets were achieved under inoculum size 50 and 500×. Hence, the graphs shown in Figure 1e,f,r,s were empty. The variations among different inoculum sizes may be due to increased competition among spores for nutrients induced by higher inoculum sizes, which prioritized proliferation over differentiation into mycelia. When the inoculum size exceeded 10 times the culture volume, sporulation occurred within 48 h, accompanied by the production of mucilaginous substances as a survival strategy, which was possibly composed of extracellular polymeric substances (EPS) [31]. Therefore, consistent with prior research [22], the optimal inoculum size for both isolates was determined to be ten times (10×) the culture volume, suggesting that lower initial inoculation concentrations positively influence microalgae–fungi composite formation.
3.1.4. Effect of Carbon Source
Aside from the inoculum size, the carbon source similarly influenced pellet formation (Figure 1g–j,t–w). Assessment of mycelial density revealed a consistent trend wherein galactose demonstrated the lowest density, contrasting with sucrose which manifested as the most favorable carbon substrate for mycelial proliferation.
3.1.5. Effects of C:N Ratio
Following the identification of the optimal carbon source, manipulation of the C:N ratio ensued, targeting ratios of 1, 25, and 50 (Figure 1k–m,x–z). Among these variations, a C:N ratio of 50 emerged as the most favorable, eliciting the highest mycelial yield for both isolates (FP and T10). Analogously, in a separate investigation, a notable enhancement (from 30% to 90%) in harvesting efficiency was achieved upon elevating the glucose concentration from 1 g/L to 2 g/L [32]. Within the scope of this study, elevating the carbon concentration of the media beyond C:N ratio 50, led to the formation of mucilaginous EPS, producing a mat-like structure instead of discrete mycelial fluffs in both isolates. This underscores that not only does the choice of carbon source impact pellet formation, but its concentration also holds critical significance.
3.2. Enzyme Activity of the Fungal Isolates
Following experimentation, FP exhibited the highest levels of reducing sugar, as determined by DNS testing, indicating its superior capacity to hydrolyze sucrose compared to T10. The adeptness of these isolates in reducing disaccharides into simpler monomeric units suggests the presence of hydrolytic enzymes critical for microalgae cell wall degradation within a co-culture context [7]. Moreover, their capability to metabolize specific organic substrates present in real wastewater, such as beverage or food processing effluents, has also been reported, for example, soy and molasses wastewater [33,34]. Cellulose activity reduced gradually over time, confirming its breakdown in the culture medium. However, it is worth noting that slight changes in laboratory conditions influence cellulose reactions, especially on Day 3, confirming its temperature dependence (Figure S1).
3.3. Molecular and Morphological Analysis of the Selected Fungal Isolates
3.3.1. Molecular Analysis
The unknown fungal isolate, designated as FP, underwent isolation procedures as outlined in Section 2.8. Microbial analysis revealed that FP is a composite fungal isolate, primarily consisting of taxa from the Ascomycota (88.72%), Mucoromycota (5.55%), Basidiomycota (5.08%), and Rozellomycota (0.65%) phyla (Figure S2A,B). The isolate’s ability to generate mycelial masses across a range of pH conditions and under stationary growth conditions can be attributed to the diverse genetic makeup of the fungal consortia. This finding aligns with the work of Jin et al. [25], who noted that isolates of the same genus, but different species, can have varying pH requirements. This suggests that the combination of characteristics from fungi of different taxa results in more complex behavior, which cannot be attributed solely to a specific genus or species. It is likely that the union of distinct isolates within FP collectively endowed it with a broad spectrum of pellet-forming capabilities, highlighting the complex interplay of genetic factors and environmental conditions that govern fungal morphogenesis.
3.3.2. Morphological Analysis
Morphological comparisons were also conducted for the fungal mycelia alone (Figure 2(ai,aii)) and the entrapped microalgae in fungal mycelia. Specifically, observation of the SEM images of the fungal mycelia of the isolate FP revealed that microalgae cells harvested by the fungi were entrapped within the fungal mycelia network (Figure 2(aiii,aiv)). This surface attachment of the microalgae cells to fungal hyphae is attributed to their opposite electrical properties [22]. These observations align with the conclusions drawn by Bhattacharya et al. [35], whose research demonstrated the capability of Chlorella pyrenoidosa cells to form durable algal–fungal pellets through the integration of cells within the hyphae of A. fumigatus pellets, resulting in efficient functionality.

Figure 2.
(a) SEM images of fungal mycelia showing rough fungal hyphae ((i) 100 µm, mag. 1000×); ((ii) 2 µm, mag. 50,000×); and harvested microalgae entrapped in fungal mycelia ((iii) 20 µm, mag. 5000×) and ((iv) 50 µm, mag. 2000×). Arrows showing entrapped microalgae cells. (b) Harvesting efficiency of isolate T10 and FP.
3.4. Harvesting Efficiency
The two isolates were examined for their HE. During the 48 h cultivation period, fungal spores developed into mycelial-like fluffs, resembling small cotton balls suspended in liquid medium. This occurred under both agitation and stationary conditions (Figure 1). The morphology of the mycelia varied depending on culture conditions, including carbon source, agitation, inoculum size, and pH. After the mycelia reached maturity, aliquots of algae culture (in the exponential growth phase) were added at 2 h intervals for harvesting experiments. Although the HI of the two isolates varied throughout the experiment, with isolate FP having a higher HI, it is worth noting that more than 95% HE was achieved within 24 h for both isolates. This indicates that isolate FP harvested the microalgae cells faster than T10, but ultimately, both isolates managed to harvest over 95% of the microalgae cells from the culture media after allowing some additional time. Microalgae cells were added intermittently as the optical density approached zero. This was performed to determine the saturation point where the fungal fluffs could no longer “absorb” or harvest the microalgae cells, as shown in Figure 2b. Larger fluffs were more efficient at harvesting microalgae than the smaller ones. The small fluffs, in particular, were obtained when galactose was used as the carbon source (Figure 3c,d).
Figure 3.
Visual observation of fluff formation in fungal isolate after 48 h (80 rpm) (a); Fungal fluff harvesting microalgae cells into microalgae–fungi composites after 24 h (b); Fungal fluffs disintegrated into tiny pieces due to fast agitation (c); Tiny fungal fluffs harvesting microalgae cells (d); Fungal fluffs showing sporulation (arrow) after 24 h (e); Microalgae–fungi composites after 24 h (f).
These structures demonstrate the superior capability in harvesting microalgae cells compared to mature fungal pellets, which become smooth and compact due to increased agitation and easy sporulation (Figure 3e). The prevalent strategies for microalgae harvesting involve co-culturing with fungal spores or pre-cultured fungal pellets [22]. Chen et al. [36] categorized these methods as Fungal Spore-Assisted (FSA) and Fungal Pellet-Assisted (FPA) microalgae harvesting, respectively. In this study, a modified FPA approach was employed, where fungi spores were allowed to develop into rough fluffs for 48 h to optimize harvesting efficiency. Prolonged cultivation led to spore germination (Figure 3e), resulting in cloudy cultures rich in EPS.
Microscopic examination revealed that microalgae can bind to fungal cells as a result of charge attraction, aside from being merely entangled within fungal hyphae [37]. This is primarily attributed to charge neutralization. Specifically, algae typically exhibit a negative surface charge, while fungi act as cationic flocculants neutralizing this charge and adsorbing microalgae cells. Additionally, the adhesive nature of microalgae to fungal hyphae can be attributed to sticky EPS secretions [21]. Factors such as divalent calcium and magnesium ions further influence flocculation by altering cell zeta potential [38]. Studies also highlight the role of surface proteins, calcium bridges, and hydrophobic interactions in microalgae–fungal pellet flocculation [27]. In this study, fungal fluffs were used to harvest microalgae at the end of their exponential growth phase. The HE of fungal isolates FP and T10 was 97.5% and 96.5%, respectively, indicating superior harvesting capabilities. Although both isolates showed comparable HE, FP exhibited a slightly higher HI, designating it as the superior candidate isolate. The degree of agitation directly impacts fungal morphology and HE, with optimal conditions favoring the formation of stable microalgae–fungal composites. Specifically, results indicate that moderate agitation leads to larger pellets (Figure 3a,b), whereas higher agitation (120 rpm) results in smaller pellet sizes due to increased pressure (Figure 3c,d). This agrees with several studies [39,40] that have pointed out that in pellet development, the energy dissipation rate of high agitating intensity results in smaller pellet sizes which become more compact and smoother as the agitating rate increases [20].
Notably, the presence of microalgae within fungal mycelia suppresses sporulation (Figure 3e,f), indicating a potential regulatory role of microalgae in fungal culture dynamics. Considering the superior role of FP in forming pellets under stationary conditions, especially under neutral or alkaline conditions (Figure 1a–z), as well as its higher HE and lower sporulation after harvesting as compared with isolate T10, FP was selected for further experimentation.
3.5. Effluent Polishing Capability
Following the successful screening of fungal isolates and selecting a superior candidate, the fungal isolate was subjected to real wastewater (FPE) to determine its potential in WWT, specifically, cocoa pulp wastewater after cocoa pulp juice production.
3.5.1. COD
The COD removal efficiencies of microalgae, fungi, and the microalgae–fungi composites were observed to be 46.10%, 44%, and 66.4%, respectively (Figure 4a). Overall, the composite showed the highest COD removal efficiency, followed by microalgae monocultures and then the fungi monocultures. This enhanced efficiency in the composite system is likely due to the synergy between microalgae and fungi. The fungal enzymes contribute to the degradation of large suspended solids, as reported by Chen et al. [41], while the microalgae benefit from the sequestration of suspended solids. Additionally, CO2 released by fungal cells is absorbed by microalgal cells, further supporting COD reduction.

Figure 4.
Nutrient removal profiles (a–d) and efficiencies (e) among microbial groups. Asterisks (*) indicate significant variations compared to the control (**** p < 0.0001).
3.5.2. NH4+-N
The interaction between fungi and microalgae also extends to nitrogen transfer, which has been demonstrated in isotopic labeling studies [42]. In particular, NH4+-N is highly favorable for microorganisms due to its low energy requirement during assimilation into amino acids [43]. This is reflected in the cultures, where the microalgae–fungi composite exhibited the highest NH4+-N reduction (82.5%), followed by microalgae monocultures (79.9%) and fungi monocultures (59.58%) (Figure 4b). Notably, this study focused on NH4+-N, as its consumption precedes that of other nitrogen forms, such as nitrate (NO3−-N), which are typically used only after NH4+-N levels are nearly exhausted [44,45]. Furthermore, nitrate (NO3−-N) levels in the original wastewater were generally undetectable.
3.5.3. PO43−-P
Phosphorus removal is influenced by both cellular metabolism and external factors such as pH and dissolved oxygen levels. When the pH reaches 8.0 or when oxygen concentrations are high, PO43−-P tends to precipitate from the medium [44]. Significant changes in PO43−-P levels were observed in the wastewater samples upon collection compared to sterilized and pH-adjusted wastewater. Previous studies indicate that the autotrophic culture of microalgae typically induces alkalinity in the medium, further contributing to the observed phosphorus removal [18]. The decrease in pH observed in the co-culture of fungi and microalgae appears to hinder the precipitation of PO43−-P. Additionally, fungi may secrete hydrolytic enzymes, such as phosphatases, which can degrade precipitated PO43−-P, thereby enhancing phosphorus assimilation by both fungi and microalgae [46]. In our study, pH levels continued to decrease across all cultures throughout the cultivation period (Figure 4d), correlating with the observed reductions in PO43−-P. The reduction efficiencies for PO43−-P were 86.2% in microalgae, 65.3% in fungi, and 92.4% in the fungi–microalgae consortium. These results suggest that the co-culture outperformed the monocultures, likely due to the synergistic interactions between both organisms. Table 2 presents examples from other studies that used microalgae–fungi composite in bio-flocculation experiments.

Table 2.
Comparison among systems using microalgae and fungi co-cultivation treating various wastewater.
3.6. Perspectives on the Performance of Microalgae–Fungi Consortia (MFC) in Wastewater
The utilization of CPW highlighted the superior efficacy of co-cultivating algae and fungi compared to their monocultures, aligning with prior research findings. This is because fungi exhibit remarkable versatility in degrading a broad range of organic substrates, including complex pollutants that may be challenging for microalgae metabolism. This synergy significantly expands the spectrum of contaminants effectively treatable in MFC systems, thereby boosting nutrient removal efficiency. Fungi, renowned for their robustness in varying environmental conditions such as pH, temperature, and nutrient availability, contribute to the stability and reliability of wastewater treatment processes. This resilience translates to reduced reliance on energy-intensive processes and chemical inputs, ultimately lowering operational costs and environmental impact in MFC systems [22]. In terms of biomass valorization, MFC systems can generate biomass with high commercial value due to their potentially enriched biochemical composition, comprising valuable compounds like lipids, proteins, and carbohydrates. This makes them promising candidates for resource recovery and secondary applications, aligning well with circular economy principles. Figure 5 outlines a process flow diagram for the implementation of MFCs in wastewater treatment systems.

Figure 5.
Experimental Process Flow Diagram.
Despite the promising potential of biological harvesting techniques, further research is necessary to enhance their efficiency, scalability, and applicability to different types of effluents. Integrating biological harvesting methods with other technologies, such as membrane filtration or electrocoagulation, could provide a comprehensive solution to enhance the performance of microalgae-based WWT systems. As research advances, these technologies may become more vital in supporting the widespread adoption of microalgae-based wastewater treatment systems, contributing to the development of more sustainable, circular, and cost-effective solutions for managing industrial effluents.
4. Conclusions
Key parameters such as pH, agitation speed, carbon source, inoculum size, and C:N ratio were optimized, each significantly influencing pellet formation. The isolate successfully produced robust fungal pellets that facilitated efficient microalgal harvesting, as confirmed by SEM analysis, which showed microalgae cells embedded within the fungal mycelia. Molecular characterization revealed that the unique pelleting ability of the fungus was due to a mixed consortium, comprising Ascomycota (88.72%), Mucoromycota (5.55%), Basidiomycota (5.08%), and Rozellomycota (0.65%). The microalgae–fungi consortia demonstrated superior nutrient removal efficiencies compared to mono-algal and fungal cultures, highlighting the positive synergistic effects of the microalgae–fungi consortia (MFC) in wastewater treatment. NH4+-N reduction was 82.5%, surpassing microalgae (79.9%) and fungi monocultures (59.6%). Correspondingly, COD removal efficiencies were 66.4%, 46.1%, and 44%, while PO43−-P reduction efficiencies were 92.4%, 86.2%, and 65.3%, respectively. This technology shows considerable potential for scaling up microalgae cultivation and harvesting processes.
Supplementary Materials
The following supporting information can be downloaded at https://www.mdpi.com/article/10.3390/w17192832/s1. Table S1: Chemical composition of minimal media used in this study. Figure S1: Enzyme activity of isolate T10 and FP. Figure S2: Relative abundance of fungi consortia; Ascomycotya (88.72%), Mucoromycota (5.55%), Basidiomycota (5.08%), and Rozellomycota (0.65%) (a); Dendrogram of taxonomic classification (b).
Author Contributions
Conceptualization, A.A.A. and S.G.; methodology, A.A.A., D.O.-M. and S.Q., J.K.D.; formal analysis, A.A.A., A.-W.A. and D.O.-M.; investigation, A.A.A., M.L. and X.L.; data curation, A.A.A., A.-W.A., M.L. and X.L.; writing—original draft preparation, A.A.A., A.-W.A., S.G. and S.Q.; writing—review and editing, M.Y.O.-A., G.K.A. and M.O.A.; visualization, A.A.A. and A.-W.A.; supervision, S.G. and S.Q.; funding acquisition, S.G. and S.Q. All authors have read and agreed to the published version of the manuscript.
Funding
National Natural Science Foundation of China: 52370040; 52470038; Natural Science Foundation of Jiangsu Province: BK20220143; National Foreign Expert Program: H20240383.
Data Availability Statement
This article contains all of the data that were created and examined during the study.
Acknowledgments
The authors would like to acknowledge the support of the Council for Scientific and Industrial Research, Water Research Institute—Ghana, the West African Center for Cell Biology of Infectious pathogens, the University of Ghana, and the Nanjing University of Science and Technology.
Conflicts of Interest
The authors declare no conflicts of interest.
Abbreviations
The following abbreviations are used in this manuscript:
| COD | Chemical oxygen demand |
| CPW | Cocoa pulp wastewater |
| EPS | Extracellular polymeric substances |
| FPE | Food processing effluent |
| HE | Harvesting efficiency |
| HI | Harvesting index |
| MFC | Microalgae–fungi consortia |
| NH4+-N | Ammonium |
| NO3−-N | Nitrate |
| NRE | Nutrient removal efficiency |
| OVAT | One-variable-at-a-time |
| PDA | Potato dextrose agar |
| PO43−-P | Phosphates |
| WWT | Wastewater treatment |
| WWTPS | Wastewater treatment plants |
References
- UN-Water. Water, Food and Energy_UN-Water. Available online: https://www.unwater.org (accessed on 24 January 2022).
- Huang, K.X.; Vadiveloo, A.; Zhou, J.L.; Yang, L.; Chen, D.Z.; Gao, F. Integrated culture and harvest systems for improved microalgal biomass production and wastewater treatment. Bioresour. Technol. 2023, 376, 128941. [Google Scholar] [CrossRef]
- Li, M.; Chen, Z.; He, Z.; Yu, S.; Shi, W.; Bi, Q.; Li, X.; Hu, J.; Qiu, S.; Ge, S. Enhanced microalgal-bacterial granulation via a novel two-stage strategy: Initial Microthrix parvicella-induced limited filamentous bulking and subsequent hydrodynamic-phototrophic synergy. Bioresour. Technol. 2025, 439, 133345. [Google Scholar] [CrossRef]
- Liu, Y.; Qiu, S.; Huang, H.; Wu, Z.; Ge, S. Ferrostatin supplementation improves microalgal activities and nutrient removal in wastewater under high temperature shock: From ferroptosis-like inhibition to enhanced oxidation resistance. Water Res. 2025, 273, 123033. [Google Scholar] [CrossRef]
- Zhang, J.; Hu, B. A novel method to harvest microalgae via co-culture of filamentous fungi to form cell pellets. Bioresour. Technol. 2012, 114, 529–535. [Google Scholar] [CrossRef]
- Zhou, W.; Min, M.; Hu, B.; Ma, X.; Liu, Y.; Wang, Q.; Shi, J.; Chen, P.; Ruan, R. Filamentous fungi assisted bio-flocculation: A novel alternative technique for harvesting heterotrophic and autotrophic microalgal cells. Sep. Purif. Technol. 2013, 107, 158–165. [Google Scholar] [CrossRef]
- Muradov, N.; Taha, M.; Miranda, A.F.; Wrede, D.; Kadali, K.; Gujar, A.; Stevenson, T.; Ball, A.S.; Mouradov, A. Fungal-assisted algal flocculation: Application in wastewater treatment and biofuel production. Biotechnol. Biofuels 2015, 8, 24. [Google Scholar] [CrossRef] [PubMed]
- Lin, C.; Cao, P.; Xu, X.; Ye, B. Algal-bacterial symbiosis system treating high-load printing and dyeing wastewater in continuous-flow reactors under natural light. Water 2019, 11, 469. [Google Scholar] [CrossRef]
- Amadu, A.A.; Abbew, A.-W.; Qiu, S.; Addico, G.N.D.; Hodgson, I.; Duodu, S.; Appiah, S.A.; Ge, S. Advanced treatment of food processing effluent by indigenous microalgae-bacteria consortia: Population dynamics and enhanced nitrogen uptake. Algal Res. 2023, 69, 102913. [Google Scholar] [CrossRef]
- Oduro-Mensah, D.; Lowor, S.T.; Bukari, Y.; Donkor, J.K.; Minnah, B.; Nuhu, A.H.; Dontoh, D.; Amadu, A.A.; Ocloo, A. Cocoa-associated filamentous fungi for the biocontrol of aflatoxigenic Aspergillus flavus. J. Basic Microbiol. 2023, 63, 1279–1292. [Google Scholar] [CrossRef] [PubMed]
- Zhang, K.; Su, Y.Y.; Cai, L. An optimized protocol of single spore isolation for fungi. Cryptogam. Mycol. 2013, 34, 349–356. [Google Scholar] [CrossRef]
- Oliveira, H.R.; Bassin, I.D.; Cammarota, M.C. Bioflocculation of cyanobacteria with pellets of Aspergillus niger: Effects of carbon supplementation, pellet diameter, and other factors in biomass densification. Bioresour. Technol. 2019, 294, 122167. [Google Scholar] [CrossRef]
- Mattam, A.J.; Chaudhari, Y.B.; Velankar, H.R. Factors regulating cellulolytic gene expression in filamentous fungi: An overview. Microb. Cell Factories 2022, 21, 44. [Google Scholar] [CrossRef] [PubMed]
- National Centre for Biotechnology Education. DNSA Reagent. 2016, pp. 1–2. Available online: https://www.ncbe.reading.ac.uk/wp-content/uploads/sites/16/2021/10/DNSAinstructions.pdf (accessed on 22 October 2022).
- Ibrahim, D. Effect of agitation speed on the morphology of Aspergillus niger HFD5A-1 hyphae and its pectinase production in submerged fermentation. World J. Biol. Chem. 2015, 6, 265. [Google Scholar] [CrossRef]
- APHA. Standard Methods for the Examination of Water and Wastewater, 21st ed.; American Water Works Association and Water Environmental Federation: Washington, DC, USA, 2005. [Google Scholar]
- Chen, Z.; Qiu, S.; Amadu, A.A.; Shen, Y.; Wang, L.; Wu, Z.; Ge, S. Simultaneous improvements on nutrient and Mg recoveries of microalgal bioremediation for municipal wastewater and nickel laterite ore wastewater. Bioresour. Technol. 2020, 297, 122517. [Google Scholar] [CrossRef] [PubMed]
- Prajapati, S.K.; Kumar, P.; Malik, A.; Choudhary, P. Exploring Pellet Forming Filamentous Fungi as Tool for Harvesting Non-flocculating Unicellular Microalgae. Bioenergy Res. 2014, 7, 1430–1440. [Google Scholar] [CrossRef]
- Serra, T.; Colomer, J.; Logan, B.E. Efficiency of different shear devices on flocculation. Water Res. 2008, 42, 1113–1121. [Google Scholar] [CrossRef]
- Nasir, N.M.; Jusoh, A.; Manan, H.; Kasan, N.A.; Kamaruzzan, A.S.; Ghani, W.A.W.A.K.; Kurniawan, S.B.; Lananan, F. Utilization of microalgae, Chlorella sp. UMT LF2 for bioremediation of Litopenaeus vannamei culture system and harvesting using bio-flocculant, Aspergillus niger. Biocatal. Agric. Biotechnol. 2023, 47, 102596. [Google Scholar] [CrossRef]
- Srinuanpan, S.; Chawpraknoi, A.; Chantarit, S.; Cheirsilp, B.; Prasertsan, P. A rapid method for harvesting and immobilization of oleaginous microalgae using pellet-forming filamentous fungi and the application in phytoremediation of secondary effluent. Int. J. Phytoremediation 2018, 20, 1017–1024. [Google Scholar] [CrossRef] [PubMed]
- Leng, L.; Li, W.; Chen, J.; Leng, S.; Chen, J.; Wei, L.; Peng, H.; Li, J.; Zhou, W.; Huang, H. Co-culture of fungi-microalgae consortium for wastewater treatment: A review. Bioresour. Technol. 2021, 330, 125008. [Google Scholar] [CrossRef]
- Zhang, J.; Zhang, J. The filamentous fungal pellet and forces driving its formation. Crit. Rev. Biotechnol. 2015, 36, 1066–1077. [Google Scholar] [CrossRef]
- Wucherpfennig, T.; Kiep, K.A.; Driouch, H.; Wittmann, C.; Krull, R. Morphology and rheology in filamentous cultivations. In Advances in Applied Microbiology; Academic Press Inc.: Cambridge, MA, USA, 2010; Volume 72, pp. 89–136. [Google Scholar] [CrossRef]
- Jin, B.; van Leeuwen, J.; Patel, B. Mycelial morphology and fungal protein production from starch processing wastewater in submerged cultures of Aspergillus oryzae. Process Biochem. 1999, 34, 335–340. [Google Scholar] [CrossRef]
- Pei, X.Y.; Ren, H.Y.; Liu, B.F. Flocculation performance and mechanism of fungal pellets on harvesting of microalgal biomass. Bioresour. Technol. 2021, 321, 124463. [Google Scholar] [CrossRef]
- Li, Y.; Xu, Y.; Liu, L.; Li, P.; Yan, Y.; Chen, T.; Zheng, T.; Wang, H. Flocculation mechanism of Aspergillus niger on harvesting of Chlorella vulgaris biomass. Algal Res. 2017, 25, 402–412. [Google Scholar] [CrossRef]
- Choi, Y.N.; Cho, H.U.; Utomo, J.C.; Shin, D.Y.; Kim, H.K.; Park, J.M. Efficient harvesting of Synechocystis sp. PCC 6803 with filamentous fungal pellets. J. Appl. Phycol. 2016, 28, 2225–2231. [Google Scholar] [CrossRef]
- Zamalloa, C.; Gultom, S.O.; Rajendran, A.; Hu, B. Ionic effects on microalgae harvest via microalgae-fungi co-pelletization. Biocatal. Agric. Biotechnol. 2017, 9, 145–155. [Google Scholar] [CrossRef]
- Prajapati, S.K.; Bhattacharya, A.; Kumar, P.; Malik, A.; Vijay, V.K. A method for simultaneous bioflocculation and pretreatment of algal biomass targeting improved methane production. Green Chem. 2016, 18, 5230–5238. [Google Scholar] [CrossRef]
- Wang, W.; Yan, Y.; Zhao, Y.; Shi, Q.; Wang, Y. Characterization of stratified EPS and their role in the initial adhesion of anammox consortia. Water Res. 2020, 169, 115223. [Google Scholar] [CrossRef]
- Billen, G.; Garnier, J. River basin nutrient delivery to the coastal sea: Assessing its potential to sustain new production of non-siliceous algae. Mar. Chem. 2007, 106, 148–160. [Google Scholar] [CrossRef]
- Yang, L.; Li, H.; Wang, Q. A novel one-step method for oil-rich biomass production and harvesting by co-cultivating microalgae with filamentous fungi in molasses wastewater. Bioresour. Technol. 2019, 275, 35–43. [Google Scholar] [CrossRef] [PubMed]
- Song, H.; Qian, J.; Fan, L.; Toda, T.; Li, H.; Sekine, M.; Song, P.; Takayama, Y.; Koga, S.; Li, J.; et al. Enhancing biomass yield, nutrient removal, and decolorization from soy sauce wastewater using an algae-fungus consortium. Algal Res. 2022, 68, 102878. [Google Scholar] [CrossRef]
- Bhattacharya, A.; Mathur, M.; Kumar, P.; Malik, A. Potential role of N-acetyl glucosamine in Aspergillus fumigatus-assisted Chlorella pyrenoidosa harvesting. Biotechnol. Biofuels 2019, 12, 178. [Google Scholar] [CrossRef]
- Chen, J.; Leng, L.; Ye, C.; Lu, Q.; Addy, M.; Wang, J.; Liu, J.; Chen, P.; Ruan, R.; Zhou, W. A comparative study between fungal pellet- and spore-assisted microalgae harvesting methods for algae bioflocculation. Bioresour. Technol. 2018, 259, 181–190. [Google Scholar] [CrossRef]
- Wrede, D.; Taha, M.; Miranda, A.F.; Kadali, K.; Stevenson, T.; Ball, A.S.; Mouradov, A. Co-cultivation of fungal and microalgal cells as an efficient system for harvesting microalgal cells, lipid production and wastewater treatment. PLoS ONE 2014, 9, e113497. [Google Scholar] [CrossRef] [PubMed]
- Rasmussen, B.; Fletcher, I.R.; Brocks, J.J.; Kilburn, M.R. Reassessing the first appearance of eukaryotes and cyanobacteria. Nature 2008, 455, 1101–1104. [Google Scholar] [CrossRef] [PubMed]
- Luo, S.; Wu, X.; Jiang, H.; Yu, M.; Liu, Y.; Min, A.; Li, W.; Ruan, R. Edible fungi-assisted harvesting system for efficient microalgae bio-flocculation. Bioresour. Technol. 2019, 282, 325–330. [Google Scholar] [CrossRef]
- Zhao, Y.; Guo, G.; Sun, S.; Hu, C.; Liu, J. Co-pelletization of microalgae and fungi for efficient nutrient purification and biogas upgrading. Bioresour. Technol. 2019, 289, 121656. [Google Scholar] [CrossRef]
- Chen, J.; Ding, L.; Liu, R.; Xu, S.; Li, L.; Gao, L.; Wei, L.; Leng, S.; Li, J.; Li, J.; et al. Hydrothermal Carbonization of Microalgae-Fungal Pellets: Removal of Nutrients from the Aqueous Phase Fungi and Microalgae Cultivation. ACS Sustain. Chem. Eng. 2020, 8, 16823–16832. [Google Scholar] [CrossRef]
- Du, Z.-Y.; Zienkiewicz, K.; Pol, N.V.; Ostrom, N.E.; Benning, C.; Bonito, G.M. Algal-fungal symbiosis leads to photosynthetic mycelium. eLife 2019, 8, e47815. [Google Scholar] [CrossRef]
- Maestrini, S.Y.; Robert, J.-M.; Leftley, J.W.; Collos, Y. Ammonium thresholds for simultaneous uptake of ammonium and nitrate by oyster-pond algae. J. Exp. Mar. Biol. Ecol. 1986, 102, 75–98. [Google Scholar] [CrossRef]
- Gonçalves, A.L.; Pires, J.C.M.; Simões, M. A review on the use of microalgal consortia for wastewater treatment. Algal Res. 2017, 24, 403–415. [Google Scholar] [CrossRef]
- Li, Z.; Chen, Z.; Xie, Y.; Hu, Y.; Xu, S.; Yu, S.; Qiu, S.; Ge, S. Dialysis-assisted control significantly enables stable long-term unaerated partial nitrification in a microalgal-bacterial consortium treating hydrolyzed urine. Bioresour. Technol. 2025, 438, 133254. [Google Scholar] [CrossRef]
- Zhang, J.; Feng, L.; Ouyang, Y.; Hu, R.; Xu, H.; Wang, J. Phosphate-solubilizing bacteria and fungi in relation to phosphorus availability under different land uses for some latosols from Guangdong, China. Catena 2020, 195, 104686. [Google Scholar] [CrossRef]
Disclaimer/Publisher’s Note: The statements, opinions and data contained in all publications are solely those of the individual author(s) and contributor(s) and not of MDPI and/or the editor(s). MDPI and/or the editor(s) disclaim responsibility for any injury to people or property resulting from any ideas, methods, instructions or products referred to in the content. |
© 2025 by the authors. Licensee MDPI, Basel, Switzerland. This article is an open access article distributed under the terms and conditions of the Creative Commons Attribution (CC BY) license (https://creativecommons.org/licenses/by/4.0/).





